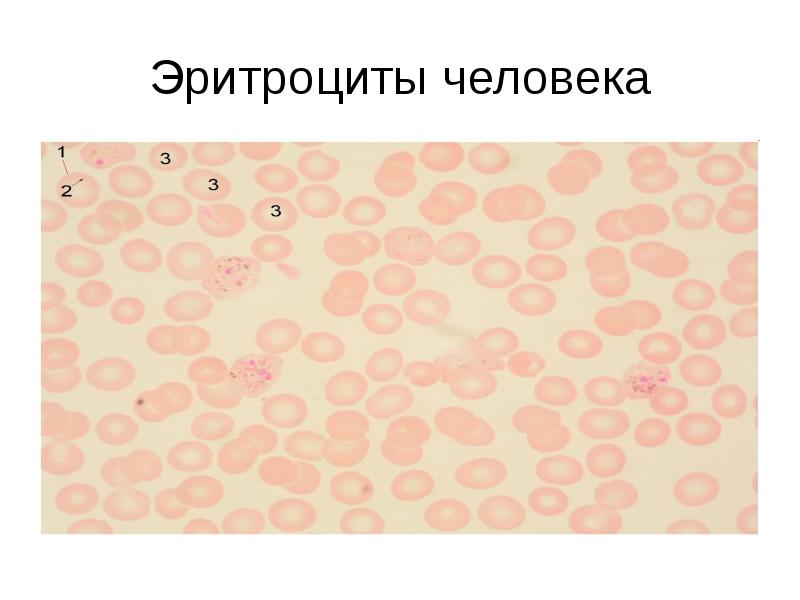
Эритроциты человека

Экзаменационные препараты презентация
Содержание
- 2. Кожица лука
- 3. Клетка кожицы лука 1. – клеточная стенка 2. – плазмалемма 3.
- 4. Жировые включения
- 5. Жировые включения 1. – мембрана клетки 2. – цитоплазма клетки 3.
- 6. Пигментные включения
- 7. Пигментные включения Пигментные зерна в клетках соединительной ткани брыжейки лягушки
- 8. Эритроциты человека
- 9. Эритроциты человека 1. – клеточная мембрана эритроцита 2. – безъядерная цитоплазма
- 10. Эритроциты лягушки
- 11. Эритроциты лягушки – эритроцит лягушки. - плазматическая мембрана эритроцита лягушки
- 12. Политенные хромосомы хирономуса
- 13. Политенные хромосомы 1 – центромера 2 – плечи хромосомы 3 –
- 14. Кариокинез в клетках корешка лука
- 15. Кариокинез в клетках корешка лука - интерфаза - профаза - метафаза
- 16. Митоз в яйце аскариды
- 17. Митоз в яйце аскариды 1. – интерфазно-профазные яйца 2. – метафаза
- 18. Амитоз в эпителии стенки мочевого пузыря лягушки
- 19. Амитоз в эпителии стенки мочевого пузыря лягушки 1 – амитотировавшие ядра
- 20. Гаструла
- 21. Бластула – однослойный многоклеточный зародыш
- 22. Яйцеклетка кошки
- 23. Сперматозоиды морской свинки
- 24. Печеночная двуустка
- 25. Печеночная двуустка Печеночный сосальщик (Fasciola hepatica) имеет размер 26-50 мм и листовидную
- 26. Шистосомы (самка, самец)
- 27. Лямблии в дуоденальном содержимом
- 28. Трипаносома в мазке крови
- 29. Лейшмания
- 30. Зрелый членик бычьего цепня
- 31. Зрелый членик свиного цепня
- 32. Зрелый членик лентеца широкого
- 33. Зрелый членик лентеца широкого Зрелый, или концевой, членик лентеца широкого Diphyllobotrium latum Ширина
- 34. Личинки трихинеллы в мышцах
- 35. Яйца широкого лентеца
- 36. Карликовый цепень
- 37. Острица самец
- 38. Острица самка
- 39. Самец и самка острицы Самец и самка острицы Enterobius vermicularis
- 40. Яйцо шистосомы Мансони
- 41. Яйцо острицы
- 42. Поперечный срез аскариды
- 43. Поперечный срез аскариды Поперечный срез самки аскариды Ascaris lumbricoides Поперечный срез тела аскариды имеет округлую
- 44. Яйцо аскариды
- 45. Яйцо аскариды Оплодотворенное яйцо аскариды Ascaris lumbricoides В поле зрения
- 46. Яйцо власоглава
- 47. Яйцо власоглава Яйцо власоглава Trichocephalus trichiurus В поле зрения микроскопа хорошо видно
- 48. Иксодовый клещ (самка)
- 49. Личинка иксодового клеща
- 50. Клоп постельный (Cimex lectularius)
- 51. Блоха
- 52. Блоха Самка человеческой блохи Pulex irritans Самка блохи имеет обтекаемую форму тела и
- 53. Вошь лобковая
- 54. Личинка головной вши
- 55. Гнида
- 56. Личинка обычного комара
- 57. Личинка малярийного комара
- 58. Куколка обычного комара
- 59. Куколка малярийного комара
- 60. Ланцетник (продольный срез)
- 61. Скачать презентацию

Слайды и текст этой презентации
Похожие презентации